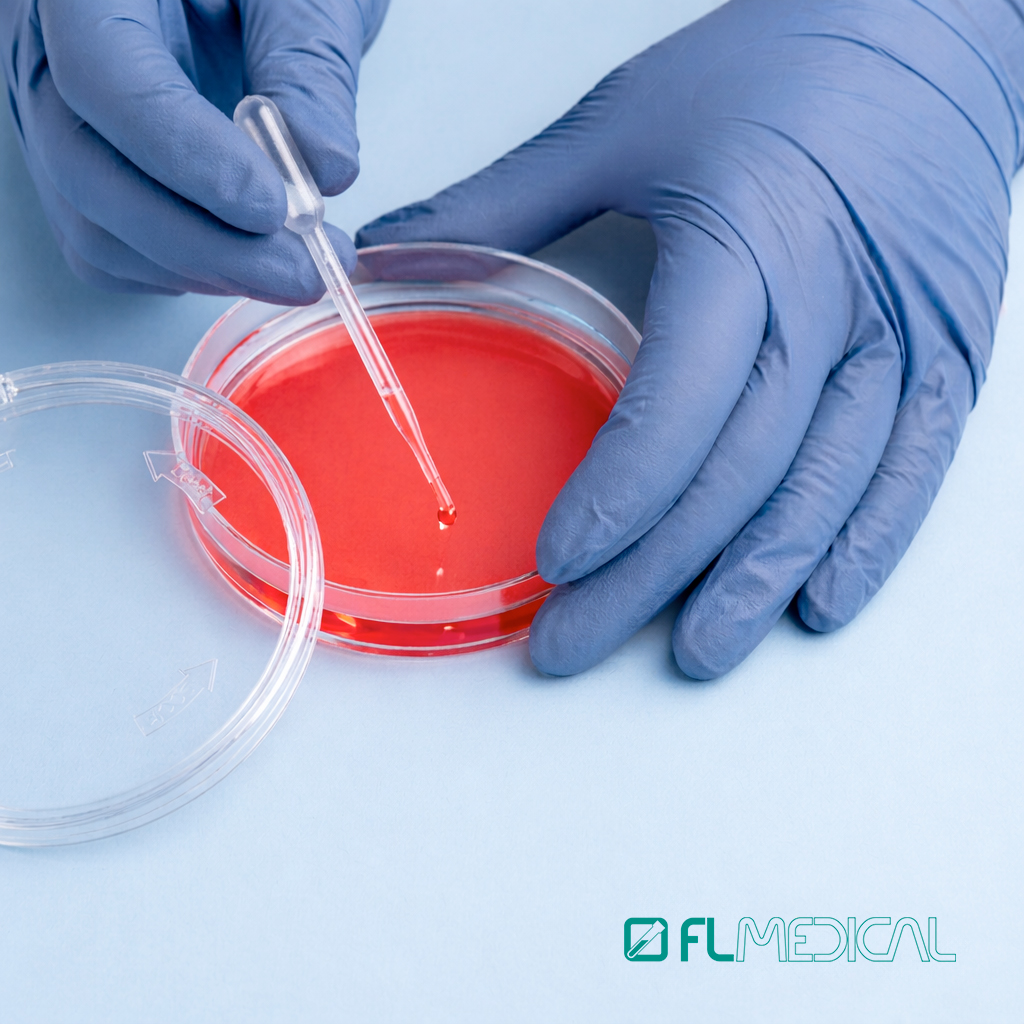
Petri 90 mm Safe-Lock: sicurezza e controllo per le analisi microbiologiche

Petri 90 mm Safe-Lock:
sicurezza e controllo per le analisi microbiologiche
Petri 90 mm Safe-Lock: sicurezza e controllo per le analisi microbiologiche
FL Medical presenta la nuova gamma di piastre Petri da 90 mm dotate dell’innovativa chiusura Safe-Lock, progettate specificamente per le esigenze del settore farmaceutico e della ricerca. Un sistema che garantisce integrità del campione e fluidità operativa in ogni condizione d’uso.
Protezione Superiore contro le contaminazioni
L’elemento distintivo delle Petri 90 mm Safe-Lock è il sistema di chiusura integrato sul coperchio. Questa caratteristica consente di mantenere la piastra chiusa durante le fasi di movimentazione, evitando che il coperchio si stacchi o cada accidentalmente.
La chiusura contribuisce in modo concreto alla protezione del campione, riducendo il rischio di contaminazioni durante l’utilizzo, l’incubazione e il trasporto. Un aspetto particolarmente rilevante nei contesti in cui è richiesta affidabilità costante e controllo delle condizioni operative.
Materiali di qualità e produzione in ambienti controllati
Le piastre sono realizzate in polistirolo, materiale che garantisce trasparenza, resistenza e un’ottima qualità ottica, facilitando l’osservazione dei campioni. Sono disponibili in versione sterile e prodotte in ambiente controllato ISO 8, in linea con gli standard richiesti per applicazioni in ambito microbiologico e farmaceutico.
Queste caratteristiche assicurano un utilizzo sicuro e conforme alle esigenze dei laboratori, contribuendo a mantenere elevati livelli qualitativi nelle attività quotidiane. Grazie alla combinazione di qualità dei materiali, sistema di chiusura e affidabilità complessiva, le Petri Safe-Lock rappresentano una soluzione che unisce sicurezza, innovazione e praticità d’uso.


















